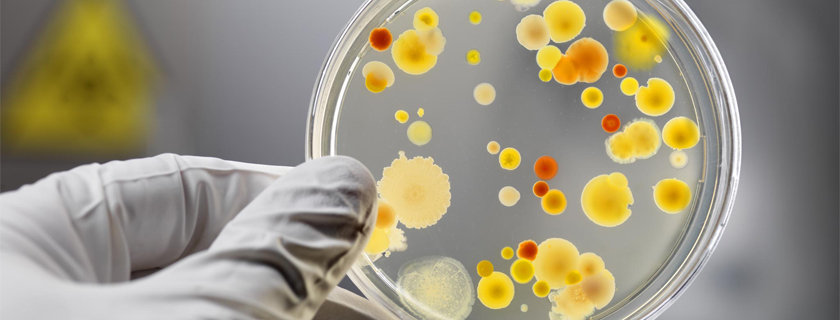

Os fungos estão por toda parte. Existem milhões de diferentes espécies de fungos na Terra, mas apenas cerca de 300 desses são conhecidos por tornar as pessoas doentes. As doenças fúngicas são frequentemente causadas por fungos comuns no meio ambiente. Os fungos vivem ao ar livre no solo e em plantas e árvores, bem como em muitas superfícies internas e na pele humana. A maioria dos fungos não é perigosa, mas alguns tipos podem ser prejudiciais à saúde.
O que são fungos?
Fungos são um reino de organismos geralmente multicelulares que são heterotróficos (não podem produzir seus próprios alimentos) e têm papeis importantes na ciclagem de nutrientes em um ecossistema. Os fungos reproduzem tanto sexualmente quanto assexuadamente, e eles também têm associações simbióticas com plantas e bactérias. No entanto, eles também são responsáveis por algumas doenças em plantas, animais e seres humanos. O estudo dos fungos é conhecido como micologia.
Leveduras, bolores e cogumelos são exemplos de fungos. Como animais, humanos e a maioria das bactérias, todos os fungos são heterotróficos. Isso significa que eles obtêm sua energia comendo substâncias orgânicas.
A maioria dos fungos é grande o suficiente para ser vista com o olho. No entanto, há alguns são organismos microscópicos e o estudo de fungos microscópicos é abrangido pelo campo da microbiologia. O grupo dos fungos microscópicos inclui as leveduras (estruturas unicelulares) e os fungos filamentosos (estruturas pluricelulares). Alguns fungos microscópicos, como por exemplo levedura, são usados na indústria de alimentos e bebidas para produzir pão, cerveja e vinho. Outros fungos são importantes nas indústrias farmacêutica e de biotecnologia e são usados na produção de antibióticos e várias enzimas. Alguns fungos estão sendo usados como probióticos.
Algumas espécies de fungos são patogênicas (organismo capaz de produzir doenças infecciosas) para animais (incluindo o homem) e plantas. Fungos patogênicos medicamente importantes incluem Candida albicans, Aspergillus fumigatus e Cryptococcus neoformans.
Características dos fungos
Alguns fungos são unicelulares, enquanto outros são multicelulares. Os fungos unicelulares são chamados de levedura. Alguns fungos alternam-se entre leveduras unicelulares e formas multicelulares, dependendo do estágio do ciclo de vida em que se encontram. As células dos fungos possuem um núcleo e organelas, como as células de plantas e animais. As paredes celulares dos fungos contêm quitina, que é uma substância dura também encontrada nos exoesqueletos de insetos e artrópodes, como os crustáceos. Eles não contêm celulose, que normalmente compõe as paredes celulares das plantas.
Fungos multicelulares têm muitas hifas, que são filamentos ramificados. As hifas têm uma forma tubular e são divididas em compartimentos semelhantes a células por paredes que são conhecidas como septos. Essas células podem ter mais de um núcleo, e os núcleos e outras organelas podem se mover entre eles. A rede de hifas de um fungo é chamada de micélio.
Os fungos são heterotróficos, eles não podem fazer seus próprios alimentos. Para fazer isso, eles usam suas hifas, que se alongam e se ramificam rapidamente, permitindo que o micélio do fungo aumente rapidamente de tamanho. Algumas hifas de fungos chegam a formar filamentos semelhantes a raízes chamados rizomorfos, que ajudam a fixar o fungo ao substrato em que ele cresce, permitindo que ele obtenha rapidamente mais nutrientes de outras fontes.
Os fungos são oportunistas, o que significa que eles podem obter nutrientes de uma ampla variedade de fontes e prosperar em uma ampla gama de condições ambientais. Alguns fungos obtêm nutrientes de matéria orgânica morta. Esses fungos são chamados de sapróbios e são decompositores, que quebram e se livram de organismos mortos. Outros fungos parasitam plantas e são responsáveis por doenças de plantas.
Reprodução de fungos
A maioria dos fungos pode se reproduzir através da reprodução sexual e assexuada. A reprodução assexuada ocorre através da liberação de esporos ou através da fragmentação micelial, que é quando o micélio se separa em múltiplas partes que crescem separadamente. Na reprodução sexual, indivíduos separados fundem suas hifas. O ciclo de vida exato depende das espécies, mas geralmente os fungos multicelulares têm um estágio haploide (onde eles têm um conjunto de cromossomos), um estágio diploide e um estágio dicariótico onde eles têm dois conjuntos de cromossomos, mas os conjuntos permanecem separados.
Todos os fungos se reproduzem usando esporos. Os esporos são células microscópicas ou grupos de células que se dispersam do fungo parental, geralmente através do vento ou da água. Os esporos podem ficar dormentes por muito tempo até que as condições sejam favoráveis ao crescimento. Esta é uma adaptação para o oportunismo, com uma disponibilidade de alimento às vezes imprevisível. Além disso, os esporos podem estar dormentes até que sejam capazes de colonizar uma nova fonte de alimento. Os fungos produzem esporos através da reprodução sexual e assexuada.
Classificação dos fungos
Existem cinco filos (classificação cientifica dos seres vivos) de fungos: Chytridiomycota, Zygomycota, Glomeromycota, Ascomycota e Basidiomycota. A seguir, uma breve descrição de cada filo.
Tipos de fungos
Chytridiomycota
Os quitrídios, os organismos encontrados em Chytridiomycota, são geralmente aquáticos e microscópicos. Eles geralmente são assexuados e produzem esporos que se movem usando flagelos, pequenos apêndices semelhantes a caudas. O Batrachochytrium dendrobatidis, que é uma espécie dos Chytridiomycota, pode causar uma infecção fúngica em rãs por escavar sob sua pele, e recentemente devastou populações de rãs, matando dois terços delas nas Américas Central e do Sul.
Zygomycota
Os zigomicetos são principalmente terrestres e se alimentam de detritos vegetais ou material animal em decomposição. Eles também causam problemas ao crescer em fontes alimentares humanas. Um exemplo de um zigomiceto é Rhizopus stolonifer. As hifas de zigomicetos não são separadas por septos, tornando seus micélios essencialmente uma célula grande com muitos núcleos. Eles geralmente se reproduzem assexuadamente, através de esporos.
Glomeromycota
Glomeromycetes compõem metade de todos os fungos encontrados no solo, e eles frequentemente formam micorrizas com plantas. Micorrizas são associações mutualistas que acontecem entre fungos e as raízes da maioria das plantas vasculares, que são aquelas que possuem vasos condutores de seivas. De fato, 80% a 90% de todas as plantas terrestres desenvolvem micorrizas com glomeromicetos. Os fungos obtêm açúcares da planta e, em contrapartida, dissolvem minerais no solo para fornecer nutrientes à planta. Além disso, esses fungos também se reproduzem assexuadamente.
Ascomycota
Os ascomicetos são frequentemente patógenos de plantas e animais, incluindo seres humanos, nos quais são responsáveis por infecções como pé de atleta, micose e ergotismo, que causam vômitos, convulsões, alucinações e, às vezes, até a morte. No entanto, alguns ascomicetes normalmente são encontrados em humanos, como a Candida albicans, uma levedura que vive nos tratos respiratório, gastrointestinal e feminino. Os ascomicetes têm bolsas reprodutivas conhecidas como ascif, que produzem esporos sexuais, mas também se reproduzem assexuadamente.
Basidiomycota
Como os ascomicetes, os basidiomicetos também produzem esporos sexuais chamados basidiósporos em células chamadas basídios. A maioria dos Basidiomycotas se reproduz sexualmente. Cogumelos são um exemplo comum desse tipo de fungos.
Doenças causadas por fungos
A maioria dos fungos não causam doenças. No entanto, alguns deles causam doenças graves. Como mencionado anteriormente, a Candida albicans cresce naturalmente dentro do corpo humano. Mas às vezes pode crescer excessivamente e causar uma infecção por fungos. As infecções por fungos são extremamente comuns, 75% das mulheres terão pelo menos uma infecção por fungos durante a sua vida.
Pessoas com um sistema imunológico enfraquecido são particularmente mais suscetíveis a doenças fúngicas invasivas.
Infecções fúngicas comuns incluem infecções fúngicas vaginais, pé de atleta, micose e candidíase oral. Menos comumente, infecções fúngicas podem se desenvolver em seus pulmões. Se você tiver uma erupção cutânea ou outros sintomas de uma infecção fúngica, consulte o seu médico para um diagnóstico preciso.
São inúmeras as doenças causadas por fungos, no entanto, algumas principais são:
- – Candidíase: infecção fúngica causada pelo fungo Candida, pode afetar a pele e órgãos genitais
- – Pano branco: infecção da pele, provocada por fungos, que é muito comum no verão, e provoca pequenas manchas descoloridas na pele
- – Tinha: chamada de “pé de atleta”, é uma infecção fúngica altamente contagiosa da pele ou do couro cabeludo
- – Esporotricose: infecção provocada por fungos que pode surgir após o contato com gatos que moram na rua
- – Aspergilose: doença pulmonar causada por fungos
- – Paracoccidioidomicose: infecção provocada pelo fungo que pode afetar diversos tecidos do corpo. O pulmão e o tegumento são os principais afetados
- – Histoplasmose: infecção respiratória causada por fungos
- – Onicomicose: infecção causada por fungos que se alimentam da queratina, proteína que forma a maior parte das unhas
Fungos na pele
As infecções da pele são causadas por uma grande variedade de fungos, e os sintomas podem variar de leves a sérios. Infecções leves podem ser tratadas com medicamentos de venda livre e remédios caseiros, enquanto outras infecções podem exigir atenção médica.
Os fungos invadem e crescem em queratina morta, uma proteína que compõe sua pele, cabelos e unhas. Os diferentes tipos de infecções fúngicas são divididos em grupos com base no tipo de fungo envolvido.
Os sintomas de uma infecção fúngica da pele dependem do tipo de fungo que a causou e de onde ela está. Erupções de fungos podem às vezes ser confundidas com outras condições de pele, como psoríase e eczema, por exemplo.
Infecções fúngicas da pele podem causar uma variedade de erupções cutâneas diferentes. Algumas são vermelhas, escamosas e com coceira. No entanto, outras podem produzir sintomas semelhante à pele seca. O fungo pode afetar apenas uma área ou várias áreas do seu corpo. Se você contrair uma infecção fúngica no couro cabeludo, poderá perder alguns cabelos.
Causas de infecções fúngicas da pele
Você tem mais chances de contrair uma infecção fúngica na pele se:
- – Está acima do peso
- – Não seca a pele completamente após um banho
- – Entrar em contato com uma pessoa ou animal com uma infecção fúngica na pele
- – Tocar em itens contaminados, como roupas, toalhas e lençóis
- – Andar descalço no chuveiro e nas áreas da piscina
- – Usar roupas apertadas que não permitem que o suor evapore
- – Ter diabetes
- – Tomar recentemente antibióticos
- – Está grávida
- – Ter um sistema imunológico enfraquecido, por exemplo, se você tem HIV/AIDS
3>Prevenção de infecções fúngicas da pele
Existem passos que você pode tomar para reduzir o risco de contrair uma infecção fúngica na pele e impedir que uma infecção se espalhe. Aqui estão algumas dicas:
- – Seque bem a pele depois de tomar um banho
- – Lave suas meias, roupas e roupas de cama regularmente para remover qualquer fungo
- – Use chinelos ou sapatos de plástico limpos em áreas comuns, como chuveiros, saunas e piscinas
- – Use roupas largas feitas de algodão ou um material respirável que é projetado para manter a umidade longe de sua pele
- – Não compartilhe toalhas, escovas de cabelo ou pentes, pois eles podem estar carregando fungos
- – Alterne seus sapatos a cada dois ou três dias para que eles tenham tempo de secar
- – Se você tem diabetes, mantenha seu açúcar no sangue sob controle
- – Se alguém da sua família tem fungos no couro cabeludo, mergulhe travesseiros, chapéus, pentes ou tesouras com água sanitária e evite usar os mesmos objetos que essa pessoa
Tratamento para fungo na pele
Você geralmente precisa usar um tratamento antifúngico que você coloca diretamente em sua pele. Estes são conhecidos como tratamentos tópicos. Há uma variedade de tratamentos disponíveis sob a forma de cremes, loções, shampoos e medicamentosos. Alguns destes estão disponíveis sem receita. Leia sempre a bula do medicamento para saber como aplicá-lo da maneira correta e por quanto tempo. Se você tiver alguma dúvida, peça conselhos ao seu farmacêutico.
Se você tem uma erupção cutânea que cobre uma grande área da pele ou afeta suas unhas ou couro cabeludo, pode ser necessário tomar comprimidos. O seu médico poderá também receitar-lhe alguns comprimidos, caso tenha utilizado um tratamento tópico e não tenha funcionado. Às vezes, os comprimidos podem causar efeitos colaterais, como irritação da pele.
Às vezes, os sintomas podem retornar, mesmo que pareçam esclarecidos. Portanto, é importante continuar usando seu tratamento por até duas semanas após os sintomas desaparecerem. Você pode precisar fazer alguns tratamentos por duas a oito semanas, ou por até um ano.
Fungos na vagina
Uma vagina saudável contém bactérias e alguns fungos. Mas quando o equilíbrio de bactérias e fungos muda, as células de fungos podem se multiplicar. Isso causa coceira intensa, inchaço e irritação.
Uma infecção por fungos vaginais, também conhecida como candidíase, é uma condição comum. Tratar uma infecção vaginal por fungos pode aliviar os sintomas dentro de alguns dias. No entanto, em casos mais graves, pode levar até duas semanas.
Sintomas de uma infecção por fungos vaginal
Infecções fúngicas vaginais têm um conjunto comum de sintomas, tais como:
- – Coceira vaginal
- – Inchaço ao redor da vagina
- – Queimação durante a micção ou sexo
- – Dor durante o sexo
- – Vermelhidão
- – Erupção cutânea
O corrimento vaginal cinza-esbranquiçado e irregular é outro sintoma revelador. Algumas pessoas dizem que esta descarga se parece com queijo cottage. Além disso, às vezes, a descarga também pode ser aguada.
Causas de infecções fúngicas vaginais
O fungo Candida é um microrganismo que ocorre naturalmente na área vaginal. No entanto, se houver um desequilíbrio no seu sistema, pode haver uma infecção. Isto leva a um crescimento excessivo de fungos, que causa os sintomas de infecções fúngicas vaginais.
Vários fatores podem causar uma infecção por fungos, incluindo:
- – Antibióticos
- – Gravidez
- – Diabetes descontrolada
- – Sistema imunológico fraco
- – Pessoas com fungos na virilha
- – Maus hábitos alimentares, incluindo muitos alimentos açucarados
- – Desequilíbrio hormonal perto do seu ciclo menstrual
- – Estresse
- – Falta de sono
Tratamento para fungo na vaginais
Para infecções fúngicas simples, o seu médico, geralmente, prescreve um regime de um a três dias de um creme, comprimido ou supositório antifúngico. Esses medicamentos podem ser prescritos ou vendidos sem receita médica.
Medicamentos comuns incluem: Butoconazol, Clotrimazol, Terconazol E Fluconazol. No entanto, se a sua infecção é recorrente, você pode desconfiar se o seu parceiro sexual tem uma infecção por fungos. Além disso, lembre-se de usar preservativos ao fazer sexo, se você suspeitar que você tem uma infecção por fungos.
Fungos nas unhas
Fungo na unha é uma infecção muito comum que faz com que as unhas se tornem quebradiças ou descoloridas. Qualquer pessoa pode desenvolver esse problema. No entanto, as pessoas mais velhas são mais propensas a desenvolver infecções por fungos do que as pessoas mais jovens.
Uma cor de unha marrom ou amarelo-esbranquiçada frequentemente sinaliza infecção ungueal por fungos. A infecção pode ser dolorosa e pode fazer com que as unhas fiquem grossas, quebradiças ou mudem de forma. A unha grande é mais provável de ser infectada com fungos nas unhas.
As pessoas com maior risco de infecção fúngica nas unhas dos pés incluem aquelas com unhas danificadas, problemas circulatórios nas pernas ou pé de atleta. Além disso, aquelas que frequentemente entram em contato com fungos em ambientes como piscinas e saunas, também estão em maior risco. Usar sapatos apertados aumenta o risco de fungos nas unhas.
Remédio para fungos na unha
O tratamento da infecção fúngica das unhas pode envolver o uso de esmaltes incolores medicados, sem receita e sem cor, que muitas vezes contêm amorolfina ou ciclopirox. Outros tratamentos tópicos incluem cremes à base de ureia, como Fluconazol ou Terbinafina, e cremes contendo bifonazol.
Os medicamentos orais, como Itraconazol ou Fluconazol, são mais eficazes do que os tratamentos tópicos no tratamento da infecção fúngica das unhas, mas também têm mais efeitos colaterais e possíveis interações medicamentosas. Itraconazol ou terbinafina são tratamentos orais comuns. Eles normalmente precisam ser tomados por pelo menos 3 meses.
Pomada para fungos
Infecções fúngicas podem ocorrer em qualquer parte do corpo e, principalmente, na pele. Para tratar essas infecções na pele, uma variedade de pomadas tópicas de prescrição ou não, estão disponíveis.
Uma das pomadas antifúngicos mais comuns é o clotrimazol. Outras pomadas antifúngicos comuns incluem:
- – Fluconazol
- – Canditrat
- – Vodol
- – Terbinafina
- – Itraconazol
- – Griseofulvina
Ao lidar com cremes antifúngicos tópicos, evite o contato com os olhos e lave as mãos antes de aplicá-los na pele. Alternativamente, é aconselhável o uso de luvas descartáveis. Aplique uma película fina na área afetada e, se desejar, cubra-a com um curativo poroso. Se você tiver uma sensação persistente de queimação, inchaço ou coceira no local da aplicação, ou se houver falta de resposta ao creme ou um agravamento dos sintomas, entre em contato com seu médico.
Remédios caseiros para fungos
Em particular, fungos parasitas se alimentam de hospedeiros vivos e são responsáveis por numerosas doenças humanas chamadas micoses, variando de infecções cutâneas a doenças respiratórias graves ou mesmo tumores. A exposição a fungos parasitas pode ocorrer pela inalação de esporos fúngicos ou pelo consumo de fungos e leveduras dos alimentos. Provavelmente, a maioria das pessoas não considera o fungo como uma possível causa raiz de seus sintomas, no entanto, muitos podem se beneficiar de remédios antifúngicos.
Alguns antifúngicos caseiros que você pode usar são:
Alho e cenoura
Alho e cenoura não são apenas poderosos antifúngicos, mas contêm uma variedade de vitaminas, minerais e outros antioxidantes. O alho contém alicina, que exibe atividade antibacteriana, antifúngica e antiparasitária. As cenouras contêm a isocumarina derivada. Um estudo de 2008 no Journal of Applied Microbiology relatou, que extratos de cenouras mostraram um efeito antimicrobiano contra uma variedade de microrganismos de origem alimentar. Beber uma combinação de suco de cenoura e alho diariamente pode ter inúmeros benefícios para a saúde e pode combater infecções fúngicas sistêmicas no corpo.
Óleos essenciais
Os óleos essenciais também possuem propriedades antifúngicas. Um estudo de 2009 da revista Foodborne Pathogens and Disease mostrou que os óleos essenciais de tomilho, orégano, cravo e laranja eram os mais eficazes contra certos fungos e bactérias. Em particular, o óleo de orégano contém compostos que destroem certos fungos tais como Aspergillus e Candida albicans. O cravo-da-índia também é eficaz contra esses fungos devido à sua alta concentração do ingrediente antifúngico ativo eugenol. Além disso, o óleo de laranja contém d-limoneno, que é frequentemente usado como um aditivo em certos desinfetantes domésticos.
Óleo de tea tree
Óleo de tea tree tem sido aprovado para ajudar a tratar fungo na unha. Uma publicação de um estudo no Journal of Antimicrobial Chemotherapy publicado em 2002, comprovou isso. O estudo diz que com base na sua ação inibitória e fungicida, o óleo de tea tree pode ser um agente útil no tratamento de infecções por dermatófitos. A revista informou que o óleo de tea tree é mais eficaz quando usado em combinação com um antifúngicos, tais como os acima mencionados. É importante notar que esse óleo pode ser levemente irritante e tem sido associado ao desenvolvimento de dermatite alérgica de contato. Portanto, isso pode limitar seu potencial como agente tópico para algumas pessoas. Além disso, o fungo nas unhas pode levar semanas a meses antes de ser completamente erradicado.
Óleo de coco
O óleo de coco também é um forte agente antifúngico e um estimulador dos intestinos, o que é importante para expulsar os micróbios indesejados do corpo. Os principais componentes medicinais do óleo de coco são o ácido láurico e o ácido caprílico, ambos ácidos graxos que previnem o crescimento excessivo de fungos. O óleo de coco pode ser tomado por via oral, usado na pele ou como parte de uma ducha vaginal, dependendo do local da infecção. Além disso, o óleo de coco também atua como um excelente hidratante da pele.
Óleo de orégano
O óleo derivado das folhas de orégano é um antimicrobiano muito potente. Geralmente deve ser diluído antes de usar, pois pode produzir sensações intensas de picadas. Seus produtos químicos medicinalmente ativos são o carvarol e o timol. O carvarcol é o antifúngico mais forte e eficaz para matar infecções sistêmicas por cândida, bem como as da pele e unhas.
Vick VapoRub
Vick VapoRub, também pode ser usado como remédio caseiro para o fungo tópico. De acordo com pesquisadores da Universidade de Michigan, da revista Phytotherapy Research, em 2003. No estudo, eles descobriram que os ingredientes desse produto, incluindo óleo de eucalipto, cânfora e mentol, foram efetivos no controle da onicomicose, uma infecção causada por fungos. Para melhores resultados, a massagem deve ser aplicada na hora de dormir e coberta com meia ou atadura. Inicialmente, a unha começa a ficar escura, o que significa que o tratamento está funcionando. Quando a unha cresce, ela deve ser aparada. Com o uso consistente, leva entre 5 e 16 meses para a infecção desaparecer completamente, que é um período de tempo comparável a alguns outros tratamentos de fungo na unha.
Bicarbonato de sódio
O bicarbonato de sódio é frequentemente usado como um remédio caseiro para o fungo nos pés ou micose. Fungos prosperam em um ambiente ácido. O bicarbonato de sódio funciona por alcalinização do pH, eliminando assim o crescimento de fungos. Bicarbonato de sódio também foi mostrado para combater infecções fúngicas ou levedura na boca. É frequentemente encontrado em creme dental e enxaguante bucal. No entanto, é importante lembrar que consumir muito bicarbonato de sódio pode ser tóxico. O uso deve ser limitado a aplicações tópicas ou como um enxaguante bucal ou enxaguar uma vez por dia.
Extratos de oliva
A oliveira era reverenciada como fonte de saúde pelos antigos gregos, que usavam muitos componentes dela. Tanto o azeite como o extrato de folhas de oliveira contêm a oleuropeína química, que é um forte antifúngico. A oleuropeína não mata fungos ou leveduras diretamente, ao contrário, perturba os ciclos reprodutivos e é capaz de reduzir populações rapidamente. A oleuropeína também reduz e estabiliza o açúcar no sangue, que age para matar leveduras e formas de fungos porque eles exigem açúcar como alimento.
-
Links que recomendamos:
- O que é candidíase e como tratar seus diferentes tipos
- Nistatina no tratamento contra candidíase oral e vaginal
- 8 remédios caseiros para tratar micose de unha rapidamente
Conclusão
A maioria das infecções fúngicas da pele podem ser tratadas com cremes vendidos sem prescrição médica. Infecções graves podem exigir métodos adicionais. É sempre melhor notificar um médico ao primeiro sinal de infecção para evitar possíveis complicações graves.